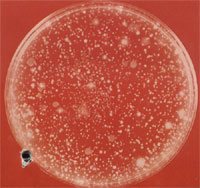
�����е�ϸ��

|
|
|
|
|
|
|
|
常容易出现湿疹,这不是因为尿本身刺激皮肤所致,而是由于细菌在残留尿液中生长并产生氨气引起的。因为氨气对皮肤有强烈刺激性。当长期不洗澡或洗脸不认真时,就可能由细菌或霉菌在身上或脸上引起皮疹,发炎, 继而流出大量的脓和污物。皮肤大面积烧伤或粘膜破损时,葡萄球菌便会侵袭创伤面而大量繁殖,引起创伤发炎溃烂;当机体着凉或疲劳过度时,在健康人的呼吸道一定能分离到的,造成典型肺炎的肺炎链球菌便会引起咽炎和扁桃体炎。龋齿是牙齿腐坏的一种常见形式,可能主要是由于正常菌群的稳定性被破坏而使某些厌氧细菌造成的。 继而流出大量的脓和污物。皮肤大面积烧伤或粘膜破损时,葡萄球菌便会侵袭创伤面而大量繁殖,引起创伤发炎溃烂;当机体着凉或疲劳过度时,在健康人的呼吸道一定能分离到的,造成典型肺炎的肺炎链球菌便会引起咽炎和扁桃体炎。龋齿是牙齿腐坏的一种常见形式,可能主要是由于正常菌群的稳定性被破坏而使某些厌氧细菌造成的。
根据1984年一位学者统计,人体正常菌群总量重达1271克,其中肠道1000克,皮肤200克,口腔、上呼吸道和阴道各占20克,鼻腔10克和眼部1克。
人体正常菌群的数量
部位
数量(每克样品)
厌氧菌:好氧菌
唾液
108-109
3-10:1
牙齿表面
109-1010
1:1
齿龈缝隙
1011-1012
102-103:1
胃
102-105
1:1
小肠近端
102-104
1:1
回肠远端
104-107
1:1
大肠
109-1012
102-103:1
阴道
108-109
5-10:1
子宫颈内膜
108-109
5-10:1

< 1 > < 2 >
|
|
|
|
|
设为首页 | 加入收藏 | 广告服务 | 友情链接 | 版权申明
Copyriht 2007 - 2008 © 科普之友 All right reserved |